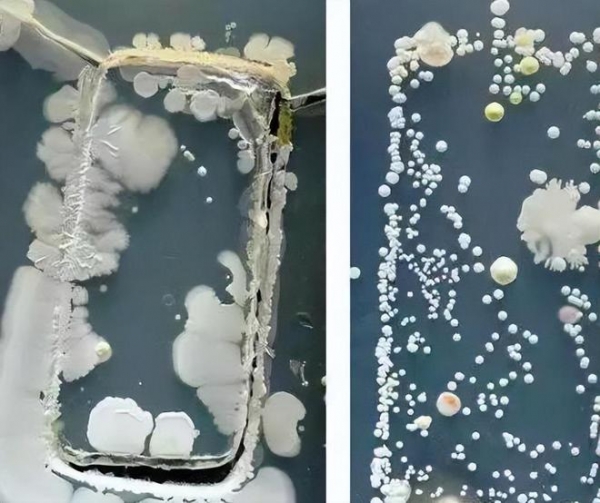
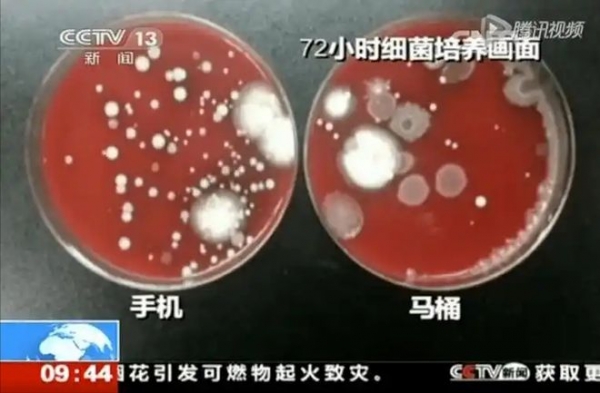

在研究的6300万部手机中,有1470万部手机存在健康威胁。
平均一部手机携带的细菌量是男厕冲水柄细菌含量的18倍。
手机细菌中包括大量的大肠杆菌及金黄色葡萄球菌,很多朋友喜欢边吃东西边打电话,手机上的细菌也许就不经意间"吃"进肚子,可能导致肠胃疾病和呼吸道疾病。
手机表面布满数以万计的细菌,在打电话时这些蠕动的细菌难免不会被擦抹到面部等部位,可能会引致暗疮、肺炎、脑膜炎等疾病。
这样的事实让人惊讶,那么事情究竟是怎回事?
手机的隐秘真相
当我们习惯性地掏出手机滑动屏幕时,很少有人会想到指尖下隐藏着一个微观世界。
18年央视曾曝光的一组实验研究就表明,我们的手机上携带着大量的细菌,当时检测人员将从来没有清洗过的手机分别提取样本,和经常被擦拭的手机接触做对比来观察培养皿里样本的变化。
让人没想到的是48小时后,每个培养皿都长满了细菌大约200多个,推算下来整部手机上的细菌数差不多要有4万了。
许多人都认为用来排泄的马桶是非常脏的,但其实马桶是利用虹吸原理来设计制作的,可以最大限度的防止脏东西逸散,甚至连马桶光滑的座圈也是被故意设计成这个样子的。

这种光滑的表面就是为了防止细菌在上面逗留,马桶就算有细菌留存大概也就每平方厘米100个,而我们的手机上面的细菌数量,大约每平方厘米1000个,对比下来就知道手机有多脏了。
说我们的手机比马桶还脏十倍真的一点也不夸张,但更令人担忧的是我们很多人吃饭时放在餐桌上,睡觉时放在枕边,甚至上厕所时也不离手。
我们每一次触碰都可能是与细菌的亲密接触,而且手机屏幕上的细菌种类繁多,大肠杆菌、金黄色葡萄球菌等都在手机上肆意繁衍。
这些细菌可以引发多种健康问题,从普通的皮肤感染到更严重的呼吸道疾病,潜在的健康风险一点也不容小觑。

要知道现在的手机普及让我们的生活更加便利,信息触手可及社交一键即达,有趣的社交媒体和手机游戏让越来越多的人日益沉浸其中。
每天早上醒来第一件事就是查看手机,入睡前最后一眼还是手机,这个习惯看似平常,却是滋生细菌的温床,那么手机携带的细菌是如何传播的?我们又该如何应对?

携带细菌的传播途径
在我们的日常生活中手机已经成为了一个无处不在的伙伴,我们用它工作、娱乐、社交,但这个看似无害的小设备,却可能是一个潜在的细菌传播媒介。

比如说生活中最常见的一幕,一边吃饭一边玩手机,看似平常的动作却可能已经完成了一次细菌的转移。
当我们触摸手机这些细菌就有机会转移到我们的手上,然后通过手指转移到了食物上最终进入人体内。

而日常生活里我们的手又总会接触过手机后不经意间触碰脸部、眼睛或食物等,从而为细菌提供了一条直达我们体内的通道。
特别是在公共场所比如餐厅、公交车或办公室,手机的细菌传播风险更高,我们可能会在这些地方接触到各种东西的表面,然后又接触使用手机。

这样一来手机就成了各种细菌的"中转站",不知不觉中将不同地方的细菌汇集在一起,更值得注意的是即便我们的手是干净的,使用手机后也可能被污染。
清洁干净的的手在使用手机通话后,仍可能受到病原体的污染,这意味着,即使我们保持了良好的手部卫生习惯,如果忽视了手机的清洁依然可能面临健康风险。

这个问题在疫情期间变得尤为突出,我们被反复提醒要勤洗手、戴口罩,但却很少有人提醒我们要定期清洁手机。
不过如果我们只注意个人卫生,却忽视了随身携带的"细菌温床",让我们的防护措施难以发挥最大效果,面对这样的情况,我们又该如何清理手机来降低细菌传播的风险呢?

清洁手机的重要性
在日常生活中,我们每天要用手机打电话、发信息、上网,甚至在吃饭时也会把手机放在桌子上,这样频繁的接触,细菌自然会在手机上滋生。
虽然我们对环境卫生有一定的关注,但手机作为我们最常接触的物品之一,往往被遗忘在了清洁的名单之外。

很多人可能会认为手机只是在手里拿着,偶尔擦拭一下就够了,可实际上细菌在手机表面生存的速度远超我们的想象。
据了解手机屏幕上细菌的数量可以在短时间内成倍增加,为了保护自己的健康,定期清洁手机显得尤为重要。

想要有效清洁手机使用消毒湿巾是一个简单而有效的方法,市面上有许多专为电子设备设计的消毒湿巾,能够有效杀灭细菌。
在使用时我们需要拆开手机壳先擦拭屏幕,然后擦手机的四角和边框,最后轻擦手机的机身,确保每个角落都能接触到湿巾的消毒成分就可以了。

或者用酒精也是一个不错的选择,最好用含有70%酒精的棉球轻轻擦拭手机,这样可以有效消毒,不过使用酒精时要小心避免让液体进入手机的缝隙以免损坏设备。
对于那些拥有更高技术要求的用户,可以考虑使用专门的手机消毒设备,这些设备通过紫外线等技术,能够在短时间内杀灭手机表面的细菌。

除了清洁的方法养成定期清洁手机的习惯也是至关重要的,建议每周至少清洁一次手机,尤其是在经历了高频使用的情况下,比如外出就餐或参加聚会后。
不过除了清洁手机来保护健康,我们还需要做什么?

良好的卫生习惯
随着科技的进步,手机等电子设备的普及使得我们必须重新审视自己的卫生习惯,虽然我们无法完全避免细菌的存在,但通过一些简单的措施,也可以有效降低细菌传播的风险。
最重要的勤洗手的习惯是最基本也是最有效的防护措施,无论是在吃饭前、上厕所后,还是在外出归来时,都应该养成洗手的习惯。

洗手时用肥皂和清水洗手至少20秒,可以有效去除手上的细菌和病毒,另外使用含有酒精的免洗洗手液也可以尤其是在没有水源的情况下。
然后每次使用手机前,尽量确保手是干净的,特别是在外出时接触了公共设施后,务必先洗手再使用手机,这样可以有效避免将细菌从手上传递到手机上。

使用手机后也要养成清洁手机的习惯,避免在不卫生的环境中使用手机也是一个重要的习惯,在公共场所,尤其是餐厅和厕所,尽量减少使用手机的频率,避免将细菌带到食物上。
另一个值得注意的细节是,尽量减少与他人共享手机,有很多人喜欢借用彼此的手机拍照或发送信息,但这无形中增加了细菌传播的风险,如果必须共享手机使用前后都要进行清洁,确保减少细菌交叉感染的可能。

同时保持良好的生活习惯也能帮助增强免疫力,均衡饮食、适量运动、充足睡眠,这些基本的生活方式都能提升身体的抵抗力,使我们更能抵御细菌的侵袭,要知道健康的身体是抵抗细菌的第一道防线。
还要关注自身的健康状况定期进行健康检查,通过定期体检,及时发现和处理潜在的健康问题,才能更好地保护自己和他人的健康。

结语
良好的卫生习惯不仅能保护自己,也能保护身边的人,在这个细菌无处不在的时代,重视卫生、保持清洁,是我们每个人都应尽的责任,只有从自身做起才能为营造一个更健康的生活环境贡献自己的力量。
手机作为我们生活中不可或缺的一部分,虽然带来了便利,却也潜藏着健康风险,通过提高对手机卫生的重视,养成良好的卫生习惯,我们可以有效降低细菌传播的风险,保护自己的健康。










